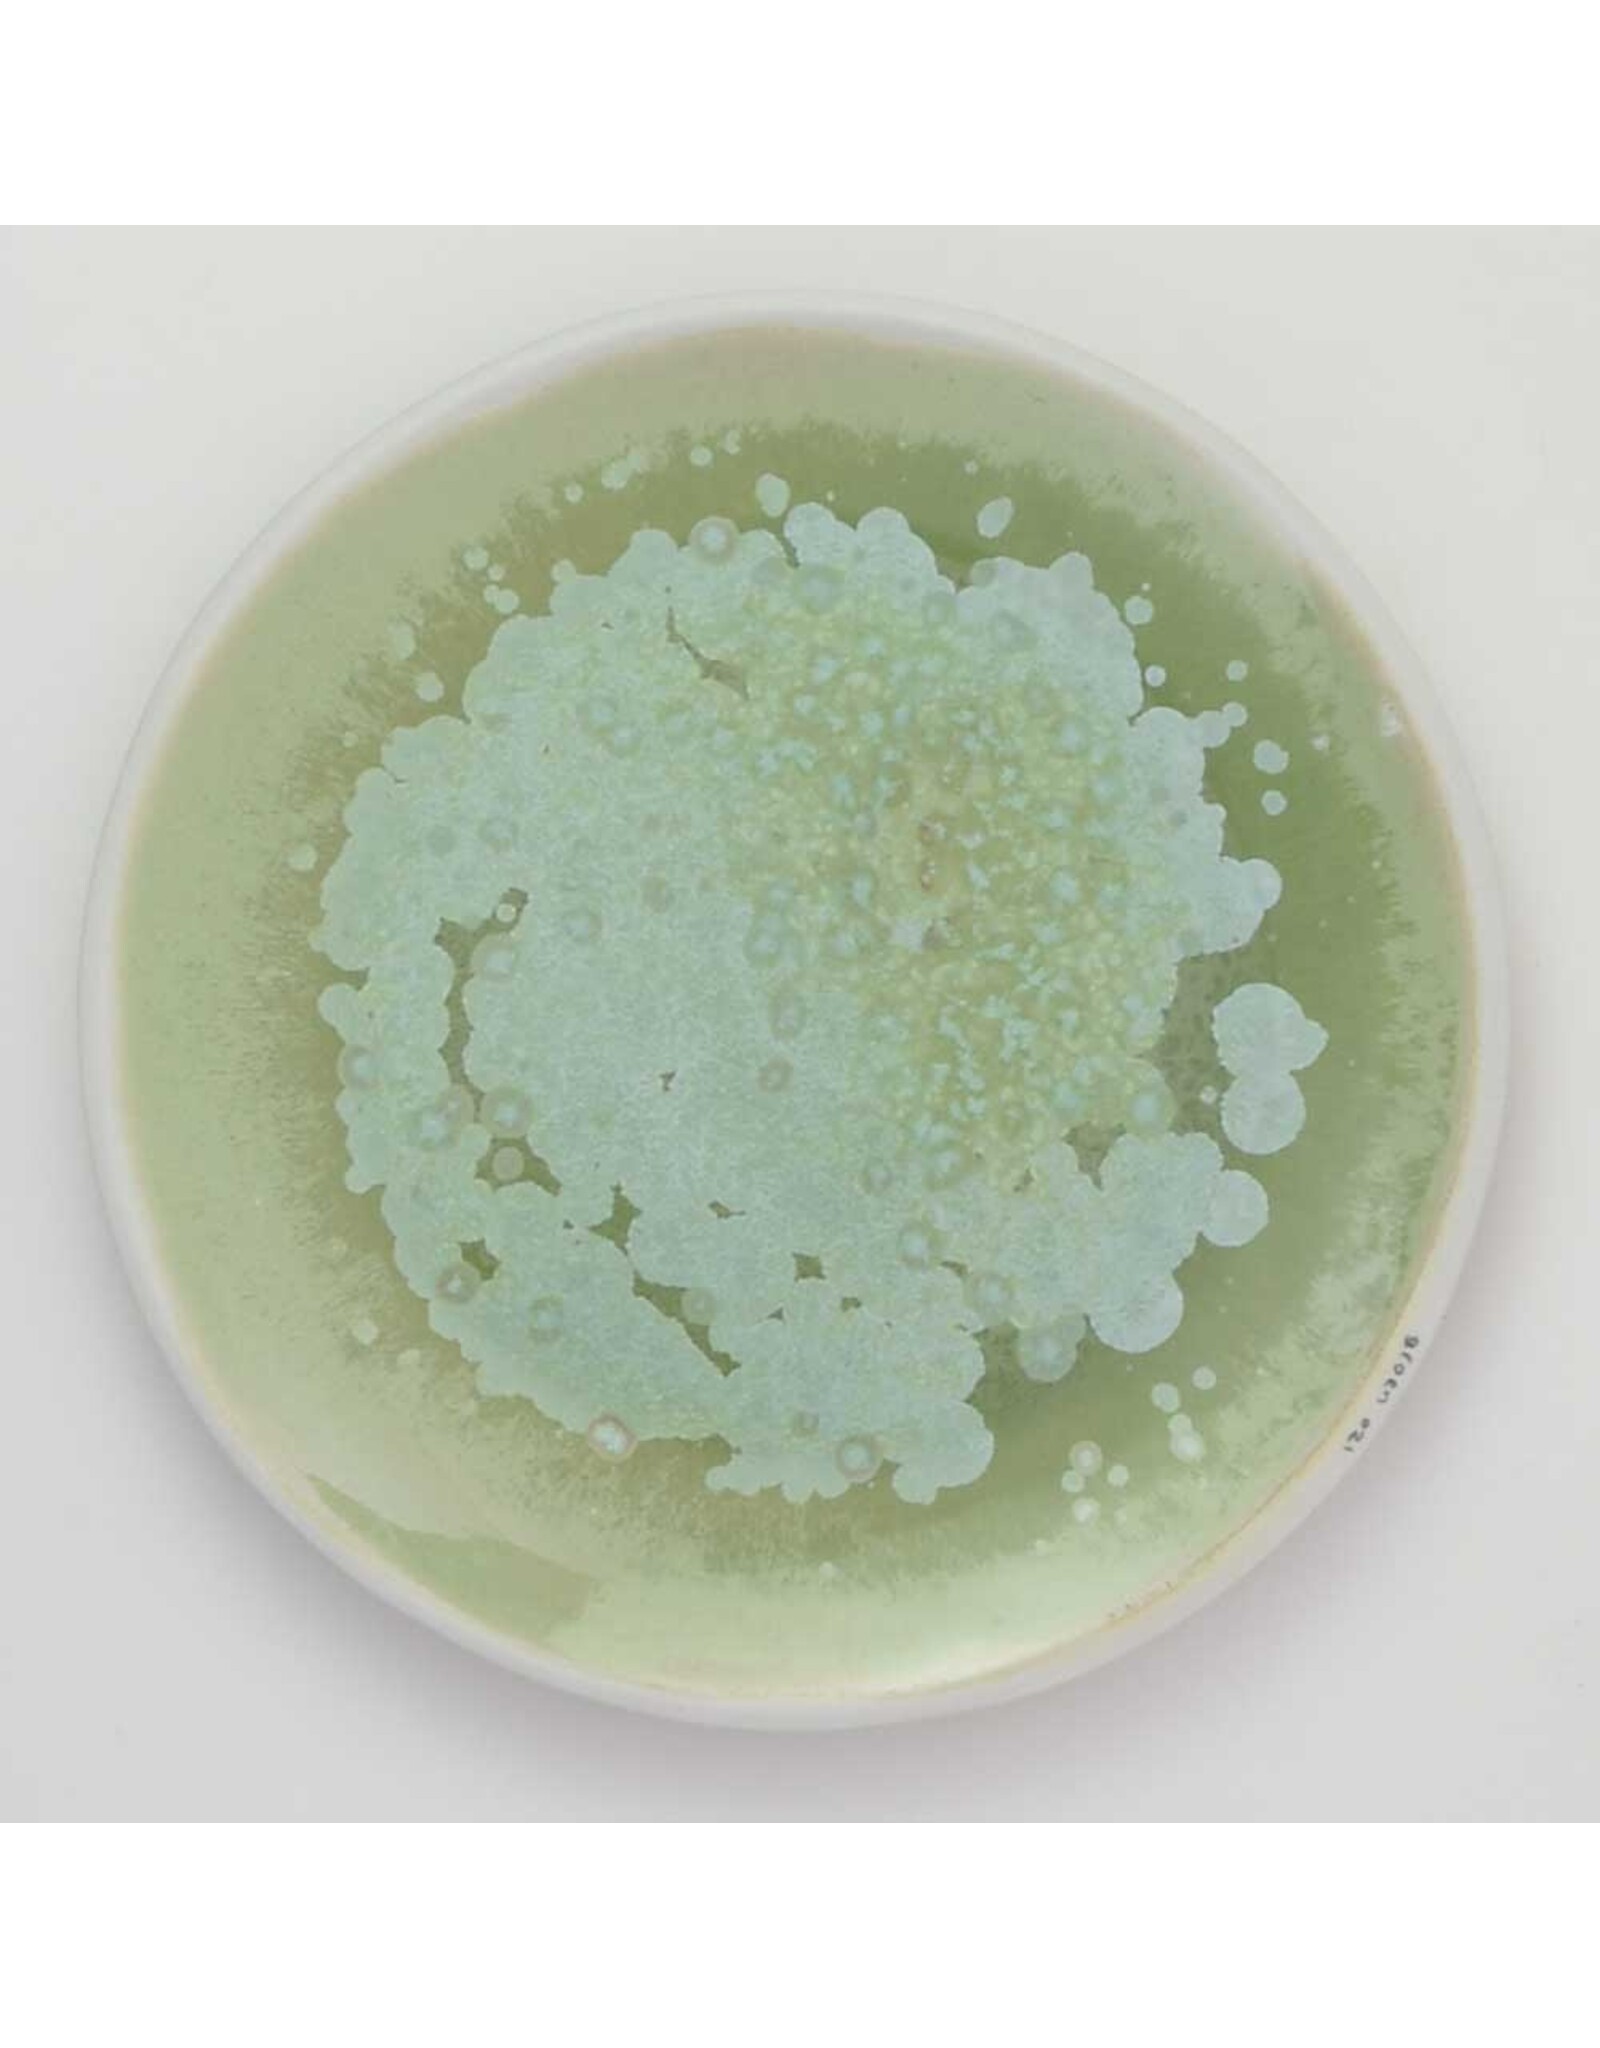
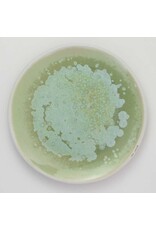

Color Dishes - Groen 021
| Beschikbaarheid: | Op voorraad (1) |
| Levertijd: | 1-5 werkdagen |
Er schuilt schoonheid in imperfectie. Dat citaat is zeker van toepassing op deze gekleurde schalen. Ooit waren dit slechts porseleinen doeken voor glazuurtests, maar nu zijn ze een enorm populair lid van onze keramiekfamilie. De eenvoudige, imperfecte vormen zijn bewust bewaard gebleven, evenals de kleurnummers op de randen, die werden gebruikt om het kleurrecept bij te houden. Het glazuur is ongelijkmatig en heeft de uitstraling van gemengde aquarel.
De kommen zijn verkrijgbaar in diverse kleuren en maten en laten zich prachtig combineren. Van een kleine versie voor dipsaus tot een grote serveerschaal met allerlei hapjes: de schalen zijn erg handig en kunnen na gebruik gewoon in de vaatwasser.
Bordafmetingen
XS Ø 9,5 cm
S Ø 11,5 cm
M Ø 15 cm